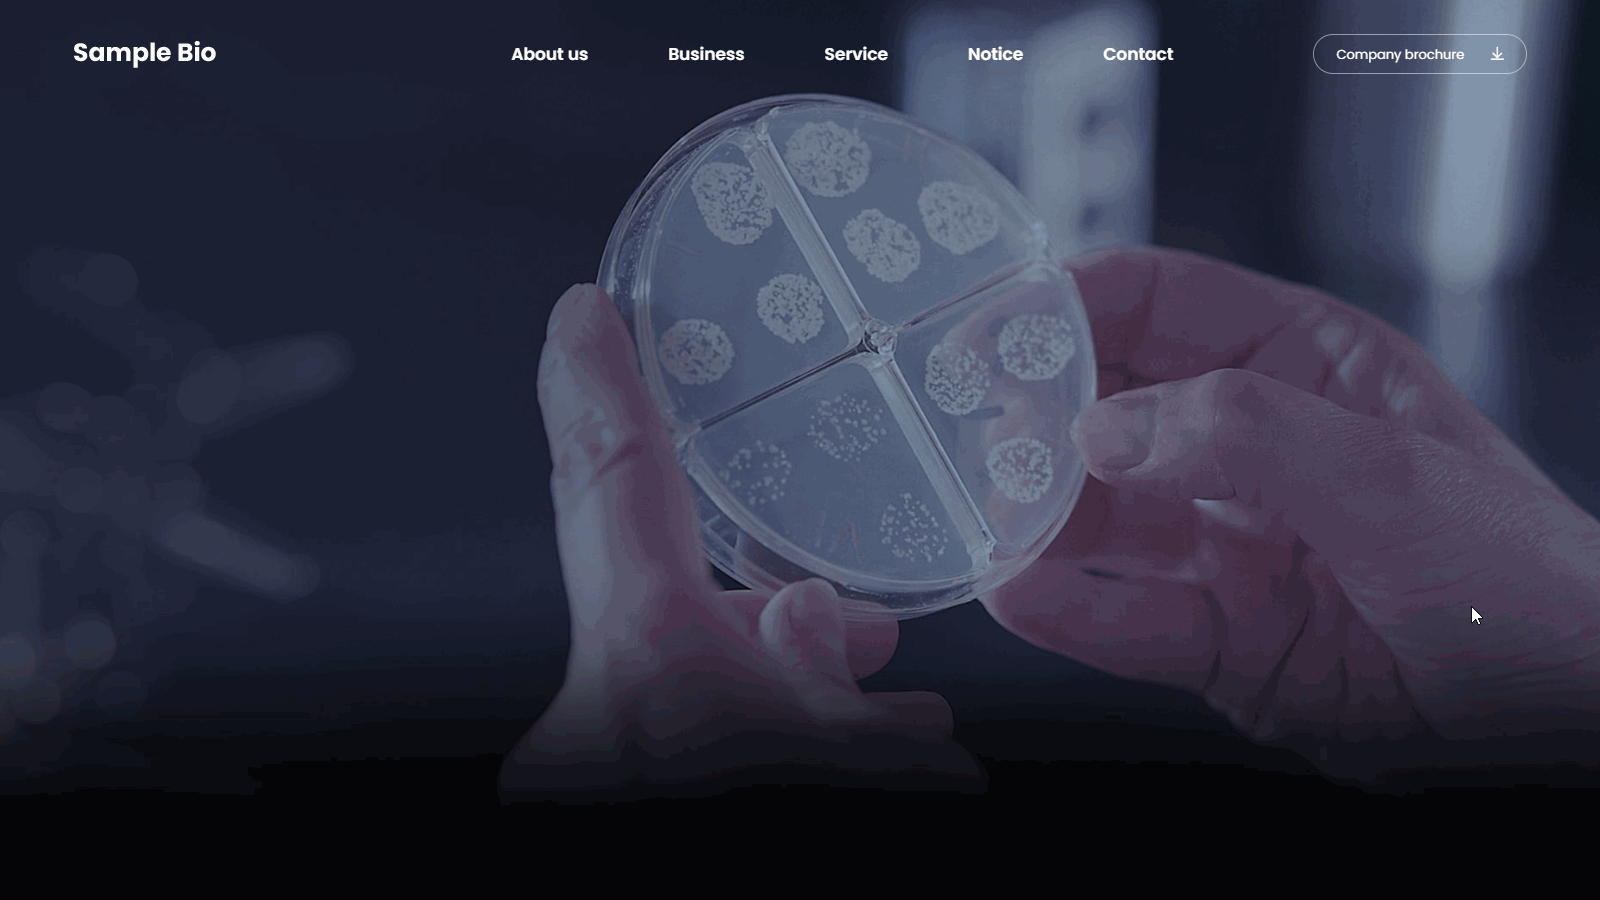
Main Page

Biotechnology Company Website UI Template
Biotech website UI template with research focus, data visuals, and professional corporate layout.Overview
A high-tech and futuristic UI template designed for biotechnology and research-based companies. It emphasizes data-driven visuals, scientific credibility, and global scalability through dark-toned design, clean layouts, and structured information delivery.biotechnology website, bio company, research institute, medical technology, biotech UI, science website, healthcare company, lab website, corporate template, tech company UI
$13.0
$45.5
Website Template Details
Template Color
Template Concept
- Trust
- Experimental
- Minimal
Template Mudiums
- Illustration
- Graphic
Template Structure
-
Main Page

about us

business

history

location

organization
Please note
- Refunds will not be issued for templates that have already been downloaded.
- If the product has not been downloaded, a full 100% refund is available.
- Refunds are also not available for accidental purchases, so please read the description and compatibility information carefully before buying.

























Comments
Have feedback on this template? Please leave a comment below.Comments that are off-topic or violate our guidelines may be hidden by the administrator.